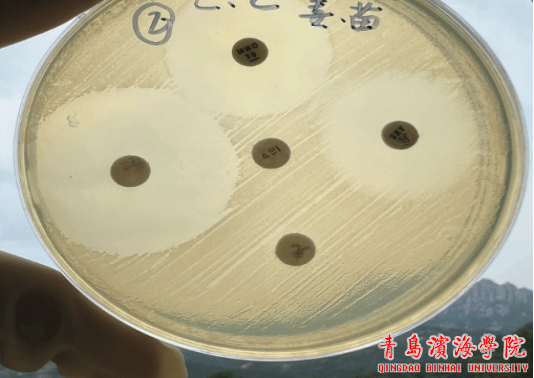

为提升医学检验技术专业教师实践教学能力,医学检验技术教研室于2025年5月21日在训德楼411实验室开展培养皿划线与菌种接种培训,特邀朴文花教授进行专业指导。
培训中,朴文花教授从微生物分离纯化的重要性切入,强调规范划线接种是保障医学检验实验准确性的关键。她结合图文课件,系统讲解分区划线法、连续划线法原理及操作要点,剖析不同菌种的接种方法,并通过临床案例阐释操作失误的影响及解决策略。

实操环节,朴教授现场示范无菌区域构建、接种环灭菌、菌种挑取及划线全流程,动作规范严谨。教师们分组练习时,手持接种环,在培养皿上细致操作。朴教授巡回指导,针对手法、划线角度等问题一对一纠正。经反复练习,教师们熟练掌握了划线接种技巧。

培训结束后,医学检验技术教研室教师围绕实操要点与教学应用展开热烈交流。老师们纷纷表示,通过本次培训掌握了划线接种的规范流程与细节把控,对微生物实验教学的精准性有了更透彻的认知。后续将开展更多技能培训,强化教师队伍建设,为培育高素质医学检验人才筑牢根基。